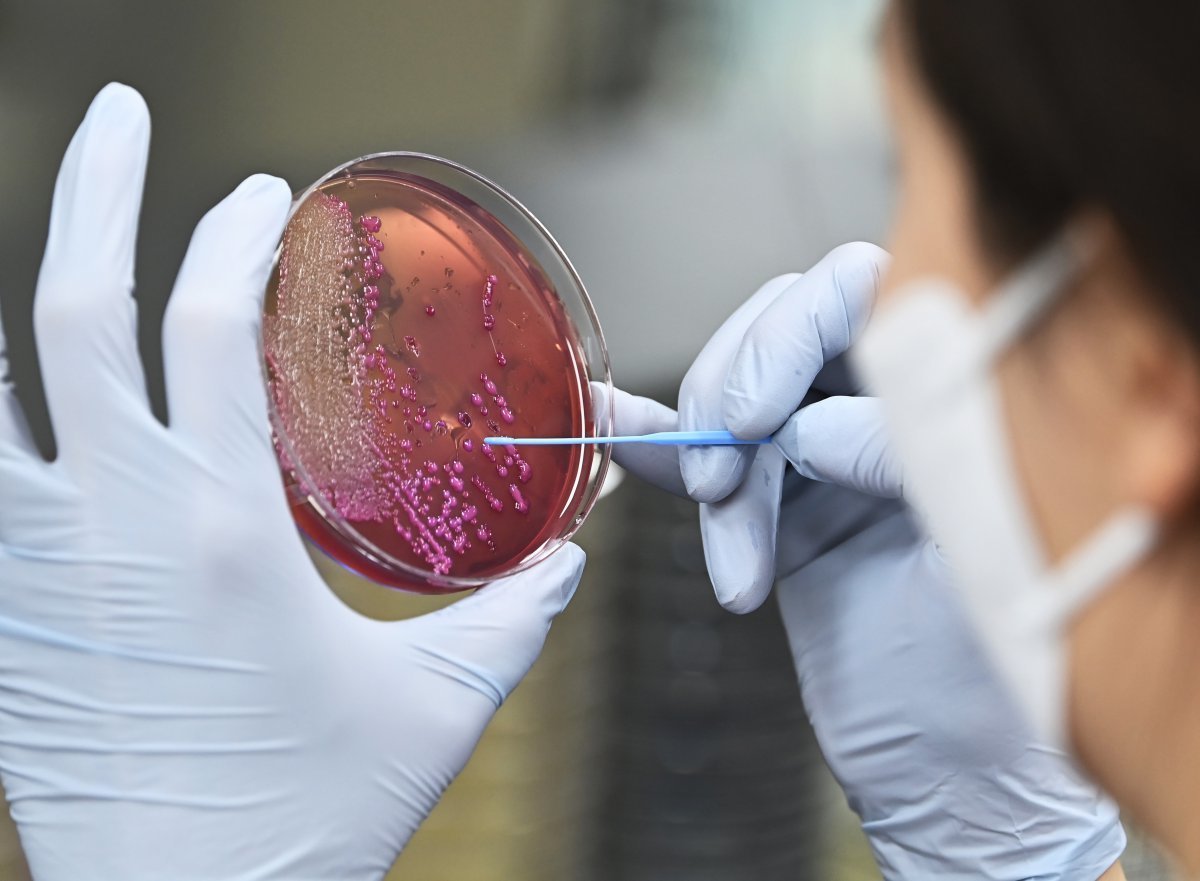

“일교차 큰 가을철, 식중독 발생에 주의하세요”
- 동아닷컴
-
입력 2024년 9월 9일 07시 11분
공유하기
글자크기 설정
식품의약품안전처(처장 오유경)가 일교차가 큰 가을철 낮에 음식을 상온에 오래 보관하거나 개인위생을 소홀히 하면 식중독 발생 가능성이 높아진다며 식중독 예방수칙 준수를 당부했다.
최근 5년(2019~2023년) 가을철 식중독 발생 현황을 분석한 결과, 발생 건수는 총 309건, 환자 수는 5976명이었으며 식중독 주요 원인은 살모넬라(48건/2068명), 병원성대장균(43건/1387명), 클로스트리디움 퍼프린젠스(21건/758명) 등이었다.
특히 음식이 살모넬라 등 식중독균에 오염되어도 냄새나 맛의 변화가 없는 경우가 많아 오염 여부를 확인하기 어려워 개인 위생관리, 끓여먹기·익혀먹기 등 식중독 예방수칙을 준수하는 것이 중요하다.
또한, 가을철 식중독의 주요 원인인 살모넬라균과 병원성대장균은 열에 약해 가열조리를 충분히 예방할 수 있으므로 육류나 가금류를 가열·조리할 때는 충분히 익혀서(중심온도 75℃, 1분 이상) 섭취해야 한다.
가열·조리 없이 섭취하는 채소류의 경우에는 염소 소독제에 5분간 담근 후 수돗물로 3회 이상 충분히 세척해야 하며, 세척·절단 등 전처리 과정을 마친 식재료를 상온에 오래 보관하면 미생물이 쉽게 증식할 수 있으므로 바로 섭취하는 것이 좋다.
칼, 도마 등 조리도구는 교차오염을 방지하기 위해 육류·생선, 채소·과일 등 식재료별로 구분해 사용해야 하며, 조리한 도구 등을 세척할 때는 그 주변에 조리 없이 바로 섭취하는 식재료나 조리된 음식은 미리 치워 세척한 물이 혼입되어 오염되지 않도록 주의해야 한다.
식약처는 “계절에 따라 증가할 수 있는 식중독 예방을 위한 정보를 지속적으로 제공하여 국민의 안전한 식생활 환경을 조성하기 위해 최선을 다할 계획”이라고 밝혔다.
© dongA.com All rights reserved. 무단 전재, 재배포 및 AI학습 이용 금지
트렌드뉴스
-
1
“인기가 샤넬백 수준”…6000원짜리 가방의 정체 [트렌디깅]
-
2
‘양정원 수사 무마’ 의혹에…강남경찰서 수사-형사과장 전원 교체
-
3
“엄마, 문 열어줘” 딸 영상통화 왔는데 CCTV 보니 ‘소름’
-
4
국힘 선대위 삐걱…“동의없이 임명” 반발에 중진 합류도 불발
-
5
삼전 노조 “영업이익 15%, 불변 아니다…중노위에 조정안 요청”
-
6
“비행기가 옆으로 넘어진다” 강풍에 아찔…조종사 “고어라운드”
-
7
“금방 돌아올게” 주왕산 초등생 끝내…탐방로 100m 벗어난 숲속서 주검으로
-
8
강수지 “골반 기울고 일자 허리”…디스크 협착 진단
-
9
“국민배당금, 사회주의식 발상…삼성·SK에 짐 더 얹을 궁리만”
-
10
“캠핑카로 옮기니 생활비 절반”…美은퇴자 새 트렌드 눈길
-
1
김용범 “AI시대 기업 초과이윤, ‘국민배당금’으로 환원돼야”
-
2
“국민배당금, 사회주의식 발상…삼성·SK에 짐 더 얹을 궁리만”
-
3
이승환, 57세 구미시장에 “4살 형이 충고한다…‘잘못했다’ 한마디면 돼”
-
4
“전재수 보좌진, 압수수색前 망치로 하드디스크 부숴 증거 인멸”
-
5
“금방 돌아올게” 주왕산 초등생 끝내…탐방로 100m 벗어난 숲속서 주검으로
-
6
안규백 “韓 주도 한반도 방위” 헤그세스 “위협적 환경, 美와 함께 해야”
-
7
삼전 노조 “영업이익 15%, 불변 아니다…중노위에 조정안 요청”
-
8
트럼프 “베네수엘라 美 51번째 주 편입 진지하게 검토”
-
9
靑, 국민배당금 논란에 “김용범 정책실장 개인 의견” 선그어
-
10
李, 수색 총력 지시했는데…국무회의 도중 주왕산 초등생 사망 비보
트렌드뉴스
-
1
“인기가 샤넬백 수준”…6000원짜리 가방의 정체 [트렌디깅]
-
2
‘양정원 수사 무마’ 의혹에…강남경찰서 수사-형사과장 전원 교체
-
3
“엄마, 문 열어줘” 딸 영상통화 왔는데 CCTV 보니 ‘소름’
-
4
국힘 선대위 삐걱…“동의없이 임명” 반발에 중진 합류도 불발
-
5
삼전 노조 “영업이익 15%, 불변 아니다…중노위에 조정안 요청”
-
6
“비행기가 옆으로 넘어진다” 강풍에 아찔…조종사 “고어라운드”
-
7
“금방 돌아올게” 주왕산 초등생 끝내…탐방로 100m 벗어난 숲속서 주검으로
-
8
강수지 “골반 기울고 일자 허리”…디스크 협착 진단
-
9
“국민배당금, 사회주의식 발상…삼성·SK에 짐 더 얹을 궁리만”
-
10
“캠핑카로 옮기니 생활비 절반”…美은퇴자 새 트렌드 눈길
-
1
김용범 “AI시대 기업 초과이윤, ‘국민배당금’으로 환원돼야”
-
2
“국민배당금, 사회주의식 발상…삼성·SK에 짐 더 얹을 궁리만”
-
3
이승환, 57세 구미시장에 “4살 형이 충고한다…‘잘못했다’ 한마디면 돼”
-
4
“전재수 보좌진, 압수수색前 망치로 하드디스크 부숴 증거 인멸”
-
5
“금방 돌아올게” 주왕산 초등생 끝내…탐방로 100m 벗어난 숲속서 주검으로
-
6
안규백 “韓 주도 한반도 방위” 헤그세스 “위협적 환경, 美와 함께 해야”
-
7
삼전 노조 “영업이익 15%, 불변 아니다…중노위에 조정안 요청”
-
8
트럼프 “베네수엘라 美 51번째 주 편입 진지하게 검토”
-
9
靑, 국민배당금 논란에 “김용범 정책실장 개인 의견” 선그어
-
10
李, 수색 총력 지시했는데…국무회의 도중 주왕산 초등생 사망 비보
-
- 좋아요
- 0개
-
- 슬퍼요
- 0개
-
- 화나요
- 0개



댓글 0